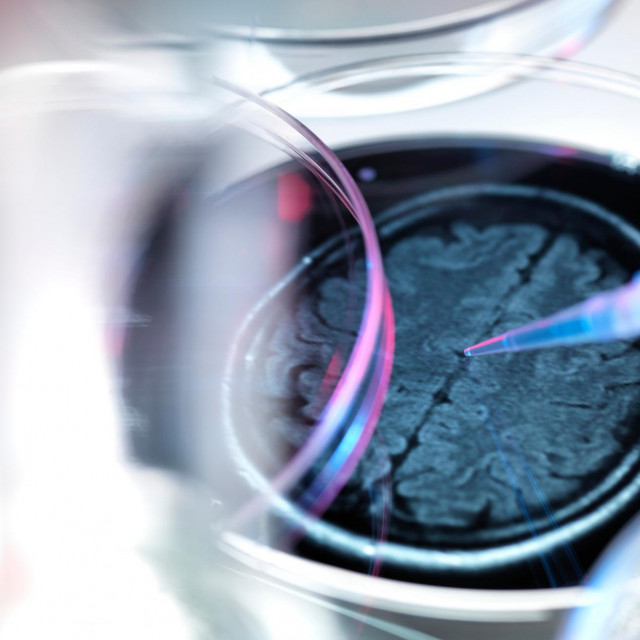
9274511

Alzheimerova bolest i ostali oblici demencije prošle su godine prvi put uvrštene među deset vodećih uzroka smrti u svijetu, objavila je Svjetska zdravstvena organizacija (WHO).
Vodeći uzrok smrti u svijetu u 2019. godini bile su bolesti srca (16 posto svih smrti ili 8,9 milijuna ljudi), zatim moždani udari (11 posto) i kronične opstruktivne bolesti pluća (šest posto).
Na četvrtom su mjestu infekcije donjih dišnih puteva, najčešći zarazni uzrok smrti u svijetu (2,6 milijuna), a na petom neonatalna stanja (dva milijuna).
No WHO napominje da je smrt novorođenčadi kategorija u kojoj je u proteklih dvadeset godina uočeno jedno od najvećih smanjenja u apsolutnim brojkama.
Istodobno raste broj umrlih od raka pluća, bronha i dušnika (respiratorne vrste raka) i globalno su šesti uz...

Za sudjelovanje u komentarima je potrebna prijava, odnosno registracija ako još nemaš korisnički profil....